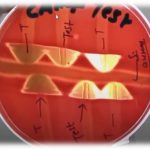
CAMP Reaction: Introduction, Principle, Test Requirements, Test Procedure, Result and Interpretation and Keynotes

Tag: camp test
Bacterial Biochemical Tests: Introduction, List of Tests, Text Link and Visual Links
 Introduction of Bacterial Biochemical Tests Bacterial Biochemical Tests is a...
Introduction of Bacterial Biochemical Tests Bacterial Biochemical Tests is a...
CAMP Reaction: Introduction, Principle, Test Requirements, Test Procedure, Result and Interpretation and Keynotes
CAMP Reaction The CAMP reaction or test is applied to...
CAMP Reaction The CAMP reaction or test is applied to...
CAMP Test: Principle, Procedure, Result and Interpretation
 CAMP Test to identify presumptively S. agalactiae The CAMP test...
CAMP Test to identify presumptively S. agalactiae The CAMP test...
